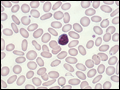

PART 2: Cardinal Manifestations and Presentation of Diseases
SECTION 10 Hematologic Alterations
e17 Atlas of Hematology and Analysis of Peripheral Blood Smears
 | Figure e17-1 Normal peripheral blood smear. Small lymphocyte in center of field. Note that the diameter of the red blood cell is similar to the diameter of the small lymphocyte nucleus. |
view large |
 | Figure e17-2 Reticulocyte count preparation. This new methylene blue–stained blood smear shows large numbers of heavily stained reticulocytes (the cells containing the dark blue–staining RNA precipitates). |
view large |
 | Figure e17-3 Hypochromic microcytic anemia of iron deficiency. Small lymphocyte in field helps assess the red blood cell size. |
view large |
 | Figure e17-4 Iron deficiency anemia next to normal red blood cells. Microcytes (right panel) are smaller than normal red blood cells (cell diameter <7 μm) and may or may not be poorly hemoglobinized (hypochromic). |
view large |
 | Figure e17-5 Polychromatophilia. Note large red cells with light purple coloring. |
view large |
 | Figure e17-6 Macrocytosis. These cells are both larger than normal (mean corpuscular volume >100) and somewhat oval in shape. Some morphologists call these cells macroovalocytes. |
view large |
 | Figure e17-7 Hypersegmented neutrophils. Hypersegmented neutrophils (multilobed polymorphonuclear leukocytes) are larger than normal neutrophils with five or more segmented nuclear lobes. They are commonly seen with folic acid or vitamin B12 deficiency. |
view large |
 | Figure e17-8 Spherocytosis. Note small hyperchromatic cells without the usual clear area in the center. |
view large |
 | Figure e17-9 Rouleaux formation. Small lymphocyte in center of field. These red cells align themselves in stacks and are related to increased serum protein levels. |
view large |
 | Figure e17-10 Red cell agglutination. Small lymphocyte and segmented neutrophil in upper left center. Note irregular collections of aggregated red cells. |
view large |
 | Figure e17-11 Fragmented red cells. Heart valve hemolysis. |
view large |
 | Figure e17-12 Sickle cells. Homozygous sickle cell disease. A nucleated red cell and neutrophil are also in the field. |
view large |
 | Figure e17-13 Target cells. Target cells are recognized by the bull's-eye appearance of the cell. Small numbers of target cells are seen with liver disease and thalassemia. Larger numbers are typical of hemoglobin C disease. |
view large |
| Figure e17-14 Elliptocytosis. Small lymphocyte in center of field. Elliptical shape of red cells related to weakened membrane structure, usually due to mutations in spectrin. |
view large |
 | Figure e17-15 Stomatocytosis. Red cells characterized by a wide transverse slit or stoma. This often is seen as an artifact in a dehydrated blood smear. These cells can be seen in hemolytic anemias and in conditions in which the red cell is overhydrated or dehydrated. |
view large |
 | Figure e17-16 Acanthocytosis. Spiculated red cells are of two types: acanthocytes are contracted dense cells with irregular membrane projections that vary in length and width; echinocytes have small, uniform, and evenly spaced membrane projections. Acanthocytes are present in severe liver... |
view large |
 | Figure e17-17 Howell-Jolly bodies. Howell-Jolly bodies are tiny nuclear remnants that normally are removed by the spleen. They appear in the blood after splenectomy (defect in removal) and with maturation/dysplastic disorders (excess production). |
view large |
 | Figure e17-18 Teardrop cells and nucleated red blood cells characteristic of myelofibrosis. A teardrop-shaped red blood cell (left panel) and a nucleated red blood cell (right panel) as typically seen with myelofibrosis and extramedullary hematopoiesis. |
view large |
 | Figure e17-19 Myelofibrosis of the bone marrow. Total replacement of marrow precursors and fat cells by a dense infiltrate of reticulin fibers and collagen (H&E stain). |
view large |
 | Figure e17-20 Reticulin stain of marrow myelofibrosis. Silver stain of a myelofibrotic marrow showing an increase in reticulin fibers (black-staining threads). |
view large |
 | Figure e17-21 Stippled red cell in lead poisoning. Mild hypochromia. Coarsely stippled red cell. |
view large |
 | Figure e17-22 Heinz bodies. Blood mixed with hypotonic solution of crystal violet. The stained material is precipitates of denatured hemoglobin within cells. |
view large |
 | Figure e17-23 Giant platelets. Giant platelets, together with a marked increase in the platelet count, are seen in myeloproliferative disorders, especially primary thrombocythemia. |
view large |
 | Figure e17-24 Normal granulocytes. The normal granulocyte has a segmented nucleus with heavy, clumped chromatin; fine neutrophilic granules are dispersed throughout the cytoplasm. |
view large |
 | Figure e17-25 Normal monocytes. The film was prepared from the buffy coat of the blood from a normal donor. L, lymphocyte; M monocyte; N, neutrophil. |
view large |
 | Figure e17-26 Normal eosinophils. The film was prepared from the buffy coat of the blood from a normal donor. N, neutrophil; E, eosinophil; L, lymphocyte. |
view large |
 | Figure e17-27 Normal basophil. The film was prepared from the buffy coat of the blood from a normal donor. L, lymphocyte; B, basophil. |
view large |
 | Figure e17-28 Pelger-Hüet anomaly. In this benign disorder, the majority of granulocytes are bilobed. The nucleus frequently has a spectacle-like, or "pince-nez," configuration. |
view large |
 | Figure e17-29 Döhle body. Neutrophil band with Döhle body. The neutrophil with a sausage-shaped nucleus in the center of the field is a band form. Döhle bodies are discrete, blue-staining nongranular areas found in the periphery of the cytoplasm of the neutrophil in infections and other toxic states. They represent aggregates... |
view large |
 | Figure e17-30 Chédiak-Higashi disease. Note giant granules in neutrophil. |
view large |
 | Figure e17-31 Normal bone marrow. Low-power view of normal adult marrow (H&E stain), showing a mix of fat cells (clear areas) and hematopoietic cells. The percentage of the space that consists of hematopoietic cells is referred to as marrow cellularity. In adults, normal marrow cellularity is 35–40%. If... |
view large |
 | Figure e17-32 Aplastic anemia bone marrow. Normal hematopoietic precursor cells are virtually absent, leaving behind fat cells, reticuloendothelial cells, and the underlying sinusoidal structure. |
view large |
 | Figure e17-33 Metastatic cancer in the bone marrow. Marrow biopsy specimen infiltrated with metastatic breast cancer and reactive fibrosis (H&E stain). |
view large |
 | Figure e17-34 Lymphoma in the bone marrow. Nodular (follicular) lymphoma infiltrate in a marrow biopsy specimen. Note the characteristic paratrabecular location of the lymphoma cells. |
view large |
 | Figure e17-35 Erythroid hyperplasia of the marrow. Marrow aspirate specimen with a myeloid/erythroid ratio (M/E ratio) of 1:1–2, typical for a patient with a hemolytic anemia or one recovering from blood loss. |
view large |
 | Figure e17-36 Myeloid hyperplasia of the marrow. Marrow aspirate specimen showing a myeloid/erythroid ratio of ≥3:1, suggesting either a loss of red blood cell precursors or an expansion of myeloid elements. |
view large |
 | Figure e17-37 Megaloblastic erythropoiesis. High-power view of megaloblastic red blood cell precursors from a patient with a macrocytic anemia. Maturation is delayed, with late normoblasts showing a more immature-appearing nucleus with a lattice-like pattern with normal cytoplasmic maturation. |
view large |
 | Figure e17-38 Prussian blue staining of marrow iron stores. Iron stores can be graded on a scale of 0 to 4+. A: a marrow with excess iron stores (>4+); B: normal stores (2–3+); C: minimal stores (1+); and D: absent iron stores... |
view large |
 | Figure e17-39 Ringed sideroblast. An orthochromatic normoblast with a collar of blue granules (mitochondria encrusted with iron) surrounding the nucleus. |
view large |
 | Figure e17-40 Acute myeloid leukemia. Leukemic myeloblast with an Auer rod. Note two to four large, prominent nucleoli in each cell. |
view large |
 | Figure e17-41 Acute promyelocytic leukemia. Note prominent cytoplasmic granules in the leukemia cells. |
view large |
 | Figure e17-42 Acute erythroleukemia. Note giant dysmorphic erythroblasts; two are binucleate, and one is multinucleate. |
view large |
 | Figure e17-43 Acute lymphoblastic leukemia. |
view large |
 | Figure e17-44 Burkitt's leukemia, acute lymphoblastic leukemia. |
view large |
 | Figure e17-45 Chronic myeloid leukemia in the peripheral blood. |
view large |
 | Figure e17-46 Chronic lymphoid leukemia in the peripheral blood. |
view large |
 | Figure e17-47 Sézary's syndrome. Lymphocytes with frequently convoluted nuclei (Sézary cells) in a patient with advanced mycosis fungoides. |
view large |
 | Figure e17-48 Adult T cell leukemia. Peripheral blood smear showing leukemia cells with typical "flower-shaped" nucleus. |
view large |
 | Figure e17-49 Follicular lymphoma in a lymph node. The normal nodal architecture is effaced by nodular expansions of tumor cells. Nodules vary in size and contain predominantly small lymphocytes with cleaved nuclei along with variable numbers of larger cells with vesicular chromatin and prominent nucleoli. |
view large |
 | Figure e17-50 Diffuse large B cell lymphoma in a lymph node. The neoplastic cells are heterogeneous but predominantly large cells with vesicular chromatin and prominent nucleoli. |
view large |
 | Figure e17-51 Burkitt's lymphoma in a lymph node. Burkitt's lymphoma with starry-sky appearance. The lighter areas are macrophages attempting to clear dead cells. |
view large |
 | Figure e17-52 Erythrophagocytosis accompanying aggressive lymphoma. The central macrophage is ingesting red cells, neutrophils, and platelets. (Courtesy of Dr. Kiyomi Tsukimori, Kyushu University, Fukuoka, Japan.) |
view large |
 | Figure e17-53 Hodgkin's disease. A Reed-Sternberg cell is present near the center of the field; a large cell with a bilobed nucleus and prominent nucleoli giving an "owl's eyes" appearance. The majority of the cells are normal lymphocytes, neutrophils, and eosinophils that form a pleiomorphic cellular infiltrate. |
view large |
 | Figure e17-54 Lacunar cell; Reed-Sternberg cell variant in nodular sclerosing Hodgkin's disease. High-power view of single mononuclear lacunar cell with retracted cytoplasm in a patient with nodular sclerosing Hodgkin's disease. |
view large |
 | Figure e17-55 Normal plasma cell. |
view large |
 | Figure e17-56 Multiple myeloma. |
view large |
 | Figure e17-57 Color serum in hemoglobinemia. The distinctive red coloration of plasma (hemoglobinemia) in a spun blood sample in a patient with intravascular hemolysis. |
view large |

